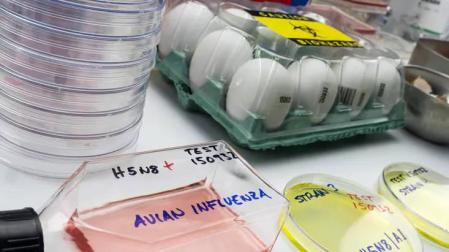
Una muestra del virus de la gripe aviar.

Detectan en Guadalajara el primer caso de gripe aviar en humanos de España
Se trata un trabajador de una granja avícola de la provincia de Guadalajara en la que se había producido un foco de gripe aviar

Publicado el 04/10/2022 a las 07:54
Un trabajador de una granja avícola de la provincia de Guadalajara, en la que se había producido un foco de gripe aviar, ha contraído la enfermedad, con lo que se convierte en el primer caso en humanos detectado en España.
Fuentes de la Consejería de Sanidad han informado a Efe de que este trabajador ha dado positivo en gripe aviar, si bien han destacado que ha sido asintomático en todo momento y que, además, el resto de sus compañeros de la granja han dado negativo en los test que se les han practicado.
Según ha adelantado Eldiario.es y han confirmado a Efe estas fuentes, se trataría del primer caso de gripe aviar en humanos de España y el segundo de Europa.
Según los primeros datos, este hombre es un trabajador de una granja avícola de Fontanar, en la que el Ministerio de Agricultura detectó un foco de gripe aviar que obligó a sacrificar a las 601.000 gallinas ponedoras de la explotación.
El foco se detectó cuando los encargados de la nave comprobaron y comunicaron un incremento anormal de la mortalidad, el 8 de septiembre, en una de las naves en jaula.
Según el Ministerio de Agricultura, la vía más probable de introducción del virus en la granja ha sido por medio de contacto con aves silvestres, dado que este año la circulación del virus entre estas aves se está manteniendo durante el verano a pesar de las elevadas temperaturas.